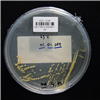

Korean Collection for Type Cultures
KCTC provides the distribution services
Find Resources
KCTC 12708
| KCTC No. | 12708 |
|---|---|
| (KCTC Other No.) | |
| Resource Type | Bacteria |
| Name | Mesonia mobilis |
| Type Strain | Yes |
| Biosafty Level | 1 |
| LMO | No |
| Synonym | |
| Phylum (ex Phylum) | Bacteroidota (Bacteroidetes) |
| Genome Information | |
| History | <- OI Nedashkovskaya, KMM, Russia |
| Source | From the sae water, Troitsa Bay, East Sea, Russia |
| Other Collection No. | KMM [6059], LMG [23670] |
| Reference | 5479 |
| KCTC Media No. |
KCTC media No. 187 Marine Agar 2216 (Difco 0979) |
| Oxygen Requirement | Aerobic |
| Temperature | 28-30 ℃ |
| pH | 7.5 |
| Incubation Time | 2 d [활성상태 계대배양 기준이므로 앰퓰, 스탁 등 장기보존체 배양의 경우 다를 수 있음] |
| Images |
|
| Price |
[Delivery form & Price]
- Freeze vial (Regular distribution): $70,000 KRW - Actively growing culture (Active culture distribution): ₩105 KRW * For regular distribution of animal cell strains to other countries, a separate dry ice fee (packing charges $500) will be added. ※ If you are picking up an animal cell strain in person, you must bring your own dry ice or liquid nitrogen. |
| MTA Restrictions | Only NON-COMMERCIAL USE for reference strains and/or academic researches |
If you use the resources sold by our KCTC for papers or patents, please make sure to write the phrase "The biological resources used in this research were distributed from KCTC"
 References
References
| Title | Jounal | Issued |
|---|---|---|
| Mesonia mobilis sp. nov., isolated from seawater, and emended description of the genus Mesonia | ijs.microbiologyresearch.org | 2006 |
| Mesonia phycicola sp. nov., isolated from seaweed, and emended description of the genus Mesonia | ijs.microbiologyresearch.org | 2010 |
| Mesonia phycicola sp. nov., isolated from seaweed, and emended description of the genus Mesonia | ijs.microbiologyresearch.org | 2010 |
| Mesonia ostreae sp. nov., isolated from seawater of an oyster farm, and emended description of the genus Mesonia | ijs.microbiologyresearch.org | 2012 |
| Mesonia aquimarina sp. nov., a marine bacterium isolated from coastal seawater | ijs.microbiologyresearch.org | 2015 |
| Mesonia hippocampi sp. nov., isolated from the brood pouch of a diseased Barbour's Seahorse (Hippocampus barbouri) | ijs.microbiologyresearch.org | 2015 |
| Mesonia | Wiley Online Library | 2015 |
| Mesonia maritimus sp. nov., isolated from seawater of the South Sea of Korea | ijs.microbiologyresearch.org | 2017 |




